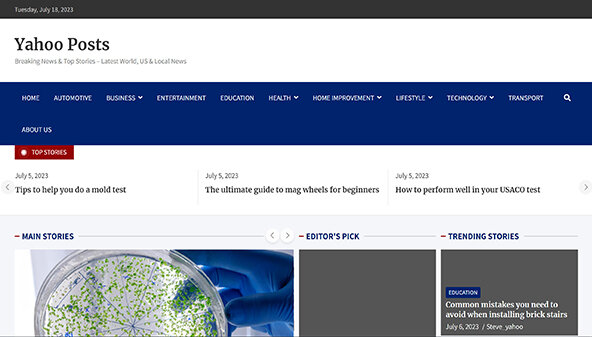

روابط إعلانية yahooposts.com
Ahrefs
Domain rank
2
كمية الزيارات
-
Ahrefs rank
39276654
Moz
سلطة النطاق:
55
الترتيب الرئيسي:
7
روابط من النطاقات:
564
البريد العشوائي:
2%
Checktrust
جودة الموقع:
سيئ
الثقة:
6%
Majestic
مجموع الروابط:
172
نطاقات الاحالة:
676
Citation Flow
24
Trust Flow
8
Trust Ratio
0.33